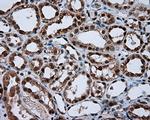
NPR3 Antibody in Immunohistochemistry (Paraffin) (IHC (P))

Search
OriGene
NPR3 Monoclonal Antibody (OTI4C3), TrueMAB™
{{$productOrderCtrl.translations['antibody.pdp.commerceCard.promotion.promotions']}}
{{$productOrderCtrl.translations['antibody.pdp.commerceCard.promotion.viewpromo']}}
{{$productOrderCtrl.translations['antibody.pdp.commerceCard.promotion.promocode']}}: {{promo.promoCode}} {{promo.promoTitle}} {{promo.promoDescription}}. {{$productOrderCtrl.translations['antibody.pdp.commerceCard.promotion.learnmore']}}
产品信息
CF501021
种属反应
宿主/亚型
分类
类型
克隆号
抗原
偶联物
形式
浓度
纯化类型
保存液
内含物
保存条件
运输条件
产品详细信息
For reconstitution, we recommend adding 100 µL distilled water to a final antibody concentration of about 1 mg/mL. To use this carrier-free antibody for conjugation experiments, we strongly recommend performing another round of desalting. (Zeba Spin Desalting Columns, 7KMWCO, 0.5 mL, Product # 89882)
靶标信息
This gene encodes one of three natriuretic peptide receptors. Natriutetic peptides are small peptides which regulate blood volume and pressure, pulmonary hypertension, and cardiac function as well as some metabolic and growth processes. The product of this gene encodes a natriuretic peptide receptor responsible for clearing circulating and extracellular natriuretic peptides through endocytosis of the receptor. Multiple transcript variants encoding different isoforms have been found for this gene.
仅用于科研。不用于诊断过程。未经明确授权不得转售。
篇参考文献 (0)
生物信息学
蛋白别名: A NPR-C; ANP-C; Atrial natriuretic peptide clearance receptor; Atrial natriuretic peptide receptor 3; Atrial natriuretic peptide receptor type C; atrionatriuretic peptide receptor C; guanylate cyclase C; natriuretic peptide receptor C/guanylate cyclase C (atrionatriuretic peptide receptor C)
基因别名: ANP-C; ANPR-C; ANPRC; C5orf23; GUCY2B; NPR-C; NPR3; NPRC
UniProt ID: (Human) P17342
Entrez Gene ID: (Human) 4883